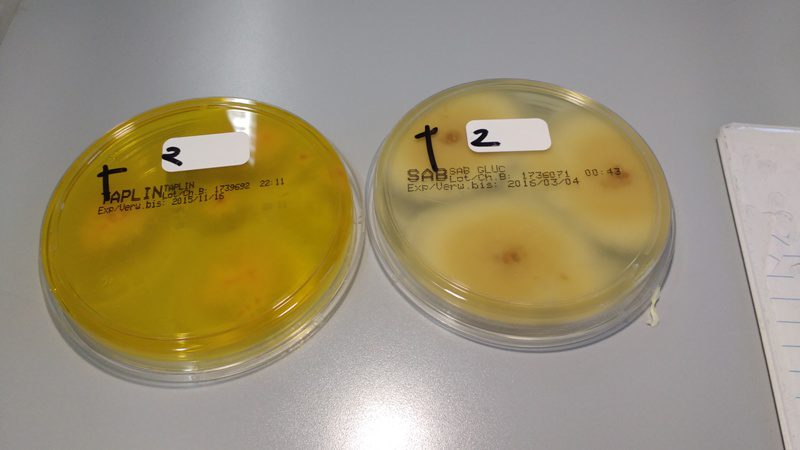
грибки в лаборатории

В связи с ухудшением экологической ситуации люди все чаще сталкиваются с инфекционными заболеваниями. Негативное влияние различных микроорганизмов в первую очередь сказывается на кожном покрове тела. Особо актуальной в настоящее время является проблема лечения микоза кожи, которым болеют не только взрослые люди, но и большинство младенцев.
Что такое микоз кожи?

В медицинской практике диагноз микоз кожи указывает на поражение кожного покрова патогенными микроорганизмами. Самыми распространенными и опасными для человека являются поражения гладкой кожи следующими грибковыми микроорганизмами:
Врачи отмечают, что микоз кожи является распространенной проблемой, с которой сталкиваются пациенты всех возрастов. Это грибковое заболевание может проявляться в различных формах, включая дерматомикоз, кандидоз и другие. Специалисты подчеркивают важность ранней диагностики и своевременного лечения, так как запущенные случаи могут привести к серьезным осложнениям. Врачи рекомендуют соблюдать правила личной гигиены, избегать контакта с зараженными поверхностями и носить свободную, дышащую одежду. Также они акцентируют внимание на необходимости консультации с дерматологом при первых признаках заболевания, чтобы избежать распространения инфекции и обеспечить эффективное лечение. Правильный подход к профилактике и лечению микозов кожи поможет сохранить здоровье и предотвратить рецидивы.
https://youtube.com/watch?v=89QJqkTwvFE
Причины развития микоза

Чем опасен микоз?

Поражать кожный покров тела могут одновременно несколько видов грибков. Микозы не проходят сами по себе, больному требуется компетентная медицинская помощь.
Если он ее не получает возможны такие осложнения, как:
Микоз кожи — это распространенная проблема, о которой говорят многие. Люди делятся своими переживаниями и опытом лечения, отмечая, что заболевание может проявляться в самых разных формах: от зуда и покраснения до шелушения и трещин. Некоторые рассказывают о том, как долго искали эффективные средства, пока не нашли подходящие кремы и мази. Другие отмечают важность своевременной диагностики и обращения к врачу, чтобы избежать осложнений. В социальных сетях можно встретить советы по профилактике, такие как соблюдение гигиены и использование индивидуальной обуви в общественных местах. Многие подчеркивают, что микоз — это не только физическая, но и психологическая проблема, так как она может вызывать дискомфорт и стеснение. В целом, обсуждение этой темы помогает людям чувствовать себя менее одинокими в борьбе с недугом и находить поддержку в сообществе.
https://youtube.com/watch?v=PwMB7EJA-5k
Симптоматика заболевания у взрослых и детей
Специалисты распознают микоз гладкой кожи по следующим обобщающим признакам протекания грибковых инфекций, которые проявляются и у взрослых, и у детей:
Микоз в детском возрасте

Микоз у детей имеет более выраженную симптоматику, может сопровождаться:
Взрослый микоз
У взрослых людей из-за длительного пребывания под ультрафиолетовыми лучами, гормональных перестроек в организме, несоблюдения правил личной гигиены диагностируется цветной лишай, себорея, онихомикоз.
Некоторые виды микозов в силу возрастного фактора способны перерастать в злокачественные кожные опухоли. Так называемый грибовидный микоз кожи (см. на фото) характеризуется образованием из опухолей незаживающих гнойных язв, приводящих к отмиранию клеток кожи – некрозу эпидермиса.
Какой специалист лечит кожные микозы?

При подозрении на грибковые инфекции целесообразным является визит к дерматологу или микологу.
Осмотр поврежденных участков кожи дает возможность доктору:
Диагностика микоза
При подозрении на грибковые инфекции выполняется углубленная диагностическая программа, предусматривающая использование:
Микроскопическому исследованию подлежат биологические материалы:
Микроскопия

Биоматериал на анализы сдается в специализированные лаборатории, выполняющие микологические исследования. Эта методика позволяет подтвердить наличие грибковой инфекции по специфически молекулярным изменениям эпидермиса, но не выявить вид грибка.
Люминесцентное свечение
Пораженные участки кожи головы просвечивают ультрафиолетом, пропущенным через специальный фильтр, что способствует выявлению поврежденных волос и подтверждению господства грибка на голове.
Культивирование грибов в лабораторных условиях
Микологическая методика подразумевает размножение грибковых колоний посредством помещения материала для исследования в благоприятную среду для культивирования инфекции в целях дальнейшего изучения ее типа.
Иммунологические пробы
Аллергическая методика позволяет выявить у больного аллергическую зависимость от грибковой инфекции. Кожные пробы на определенные грибковые инфекции позволяют установить причину иммунологической реакции организма на тот или иной вид грибка.
Биологические методы исследования
Основой биологических методов обнаружения грибковых инфекций является изучение негативного влияния инфекции на животных, заражение которых происходит через биоматериал, собранный на больных людях.
Серологические методы
Позволяют обнаружить в сыворотке крови специфические антитела, указывающие на то, что организм борется с грибковыми инфекциями.
Гистологический анализ

Представляет собой процедуру изучения под микроскопом среза тканей, которая позволяет выявить злокачественные опухоли и новообразования на коже.
В целях всестороннего обследования организма больной микозом по рекомендации специалистов проходит все вышеперечисленные процедуры. Особенно актуально это делать при остром протекании микоза, частых рецидивах.
Чем лечить микоз кожи?
Микоз кожи является сложным диагнозом в силу того, что его могут провоцировать различные виды грибковой инфекции.
Его лечение выполняется поэтапно:

И у взрослого человека, и у ребенка микоз кожи лечится комплексно. Разница в терапии заключается лишь в выборе препаратов.
Детям назначаются лекарства с минимальным перечнем возможных побочных эффектов.
Стандартный протокол лечения кожных микозов

В целях облегчения состояния больного специалисты назначают:
Как таковой единой схемы лечения кожных микозов не существует.
Тактика медикаментозной терапии и ее продолжительность зависят от таких факторов, как:
Часто используемые препараты в лечении детских микозов

|
Наименование препарата |
Форма выпуска |
Фармакологические свойства |
Применение |
|
«Йод» |
спиртовая настойка |
дезинфицирующий препарат, антисептик |
обработка поверхностных очагов грибковой инфекции по всему телу |
|
Салициловая мазь антибиотики |
мази |
антибактериальные антисептики |
|
|
Серно-дегтярная мазь |
|||
|
«Микоспор» |
раствор |
противомикозные средства |
обработка кожи пальцев рук, ног и ногтей |
|
«Пимафуцин» |
крем |
||
|
«Ламизил» |
гель |
||
|
«Нистатин» |
мази |
увлажнение пораженных участков тела, снятие зуда |
|
|
«Амфотерицин А» |
|||
|
«Миконазол» |
|||
|
«Гризеофульвин» |
таблетки |
антибактериальный препарат |
угнетение развития грибков |
|
Витамины А,В,С,D, Е |
драже, капсулы, жевательные таблетки |
витаминные комплексы |
способствуют восстановлению кожного покрова |
|
«Иммунал» |
капсулы, таблетки |
иммуностимуляторы |
способствуют укреплению иммунной защиты организма |
|
«Деринат» |
|||
|
«Амиксин» |
Препараты, используемые в лечении кожных микозов взрослых людей

|
Наименование препарата |
Форма выпуска |
Фармакологические свойства |
Применение |
|
«Флуконазол» |
таблетки |
антибактериальные препараты |
угнетение развития грибка, лечение лишайных образований на коже |
|
«Тербинафин» |
|||
|
«Итраконазол» |
|||
|
«Кетоконазол» |
|||
|
«Эконазол», |
мази, кремы, спреи |
противомикозные препараты наружного применения |
увлажнение пораженных участков тела, снятие зуда |
|
«Миконазол» |
|||
|
«Бифоназол» |
|||
|
«Клотримазол», |
|||
|
«Оксиконазол» |
|||
|
«Ифенек», |
|||
|
«Ламизил» |
|||
|
«Экзифин» |
|||
|
«Микосептин» |
|||
|
Ирунин» |
мази, кремы |
обработка кожи пальцев рук, ног и ногтей |
|
|
«Лоцерил» |
|||
|
«Батрафен» |
|||
|
«Клотримазола» |
растворы |
противовоспалительные средства |
подсушивание влажных очагов поражения грибковой инфекцией |
|
«Кастеллани» |
|||
|
Салициловая мазь |
мази |
антибактериальные антисептики |
|
|
Серно-дегтярная мазь |
|||
|
«Микозолон» |
|||
|
«Эсулан» |
|||
|
«Калий перманганата» |
раствор |
антисептики |
обработка при микозе кожи головы пораженных участков, лечение ороговевших очагов инфекции |
|
«Фурацилин» |
|||
|
«Хлоргексидин» |
|||
|
«Ихтиол» |
|||
|
«Тиосульфат натрия» |
раствор |
десенсибилизирующие, антигистаминные препараты |
лечение аллергических реакций, экземоподобных кожных образований на теле |
|
«Кальция глюконат» |
|||
|
«Цетрин» |
таблетки |
||
|
«Тавегил» |
|||
|
«Кларетин» |
|||
|
«Эдем» |
|||
|
«Низорал» |
кремы |
противогрибковые средства |
лечение лишая |
|
«Микозон» |
|||
|
«Дексаметазон» |
раствор |
кортикостероиды |
лечение грибовидного микоза |
|
«Преднизолон» |
раствор |
||
|
«Проспидин» |
мазь |
противоопухолевые антибиотики |
|
|
«Сульфадиазин» |
таблетки |
||
|
«Метотрексат» |
раствор |
||
|
Витамины А,В,С,D, Е |
таблетки, драже |
витаминные комплексы |
способствуют восстановлению кожного покрова |
|
«Иммудон» |
таблетки |
иммуностимуляторы |
способствуют укреплению иммунной защиты организма |
|
«Ликопид» |

При остром протекании микозов целесообразными являются такие процедуры, как:
Народная противомикозная терапия
В борьбе с грибковыми инфекциями кожи эффективными являются травы:

Вышеперечисленные травы содержат в своем составе ядовитые вещества, которые пагубно влияют на большинство разновидностей грибковых инфекций.
С этими травами делают спиртовые настойки либо мази на вазелиновой основе, которыми обрабатывают пораженные участки кожного покрова тела. Травяные примочки и компрессы способствуют снятию воспаления поврежденного эпидермиса, зуда, ускоряют процесс отшелушивания мертвых частиц, за счет чего происходит заживление язв.
Профилактические мероприятия

В силах каждого человека предотвратить заражение грибковыми инфекциями. Соблюдая следующие профилактические мероприятия, можно навсегда забыть о такой проблеме, как микоз кожи:
https://youtube.com/watch?v=89QJqkTwvFE
Вопрос-ответ
Как выглядит микоз на коже?
Характерны единичные или множественные ярко-красные округлой формы возвышающиеся высыпания. Пятна постепенно увеличиваются, их поверхность покрывается тонкими чешуйками, а по периферии возникают мелкие пузырьки, которые могут локализоваться на любом участке кожи.
Отчего появляется микоз?
Причины развития патологии. Основной причиной микоза является заражение патогенным грибком. В то же время многие виды грибов постоянно присутствуют в организме, а их рост обычно сдерживается иммунной системой. При снижении контроля грибок начинает разрастаться на коже или тканях внутренних органов.
Советы
СОВЕТ №1
Регулярно проверяйте состояние кожи, особенно в местах, подверженных повышенной влажности, таких как между пальцами ног и подмышками. Обратите внимание на любые изменения, такие как покраснение, зуд или шелушение, и при первых признаках микоза обращайтесь к врачу.
СОВЕТ №2
Поддерживайте хорошую гигиену. Регулярно мойте и тщательно высушивайте участки кожи, особенно в складках. Используйте антибактериальные мыла и избегайте общих полотенец и обуви, чтобы снизить риск заражения.
СОВЕТ №3
Выбирайте удобную и дышащую обувь. Избегайте тесной и синтетической обуви, которая может создавать влажную среду для грибков. Носите носки из натуральных материалов, которые хорошо впитывают влагу.
СОВЕТ №4
Укрепляйте иммунную систему. Правильное питание, регулярные физические нагрузки и достаточный сон помогут вашему организму лучше справляться с инфекциями, включая микозы. Рассмотрите возможность приема витаминов и минералов, особенно в осенне-зимний период.










